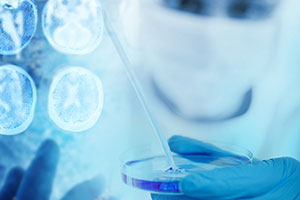

颅底肿瘤是指颅底和其相邻近结构,有些肿瘤由颅内向颅外或由颅外向颅内,通过颅底裂孔,或破坏颅底骨质后,在颅内生长。因此部分瘤体位于颅内,而部分瘤体位于颅外。颅底肿瘤种类较多,临床上以前、中和后三个颅窝底范围划分,通常以脑膜瘤、神经鞘瘤、脊索瘤、垂体瘤、颅咽管瘤、海绵窦肿瘤等多见,会损害视丘下部及周围的结构,引起内分泌功能紊乱,视力、视野损害和颅内压增高。
随着显微神经外科、神经内镜技术、神经导航技术、立体定向技术的进步和完善,颅底肿瘤手术向着微创化的方向发展。手术定位更准确,病灶切除更完全,并发症少,实现了准确性、灵活性、微创性及快速性的高度统一,使神经外科微创手术真正进入了“微侵袭”时代。
颅底肿瘤有哪些症状? 颅底肿瘤是指颅底及其相邻近结构,有些肿瘤由颅内向颅外或由颅外向颅内,通过颅底裂孔或破坏颅底骨质后在颅...【详细】
目前对颅底肿瘤的治疗,采取综合治疗手段,即手术治疗、放射治疗、化学治疗、中医药治疗等。因为患者对治疗的耐受程度、敏感性、...【详细】


